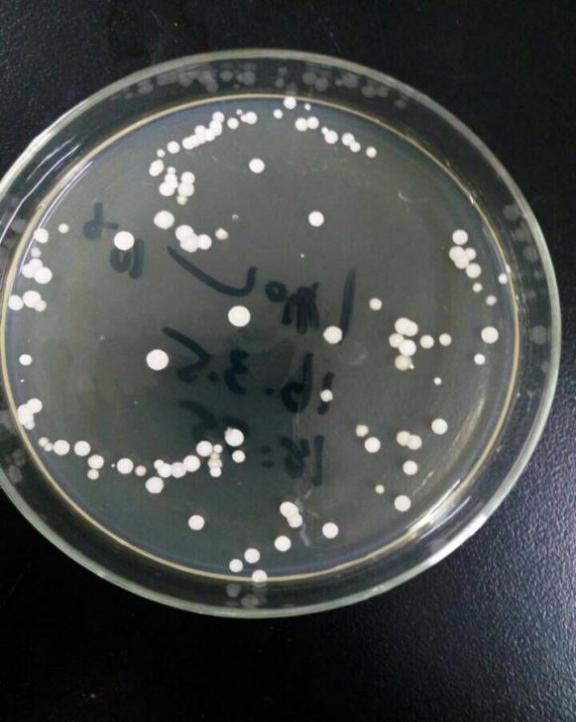
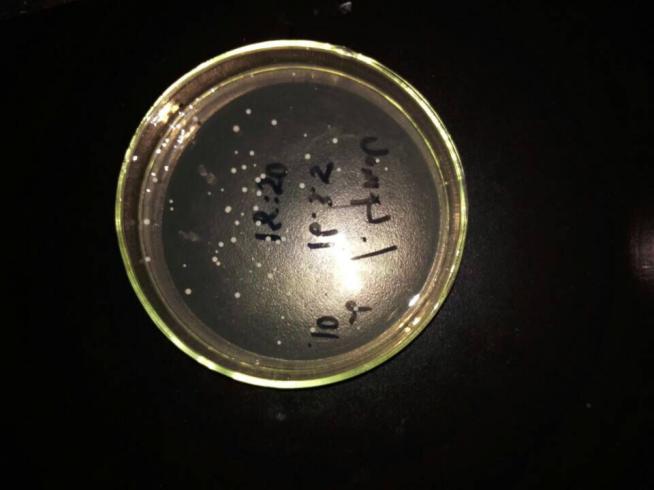
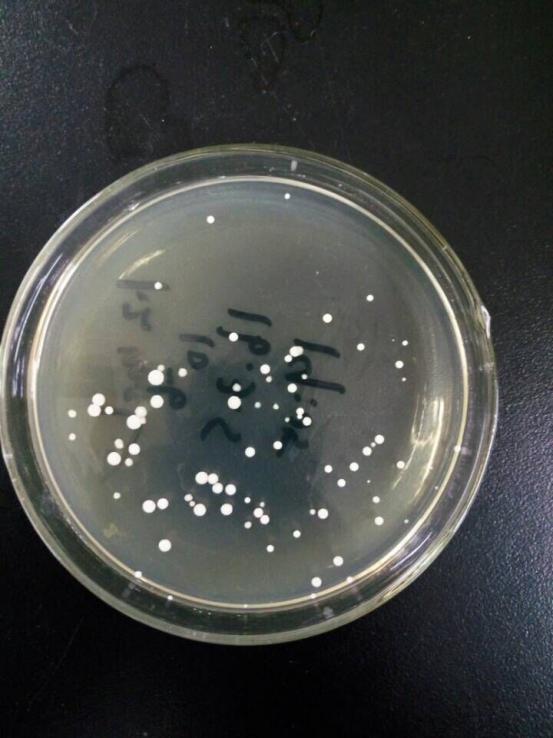
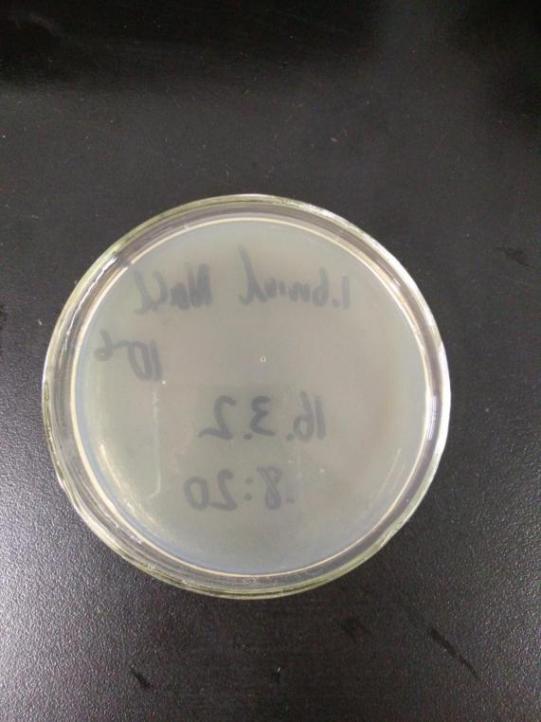
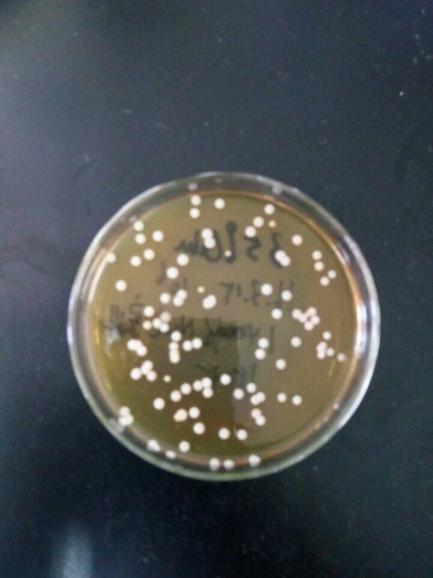
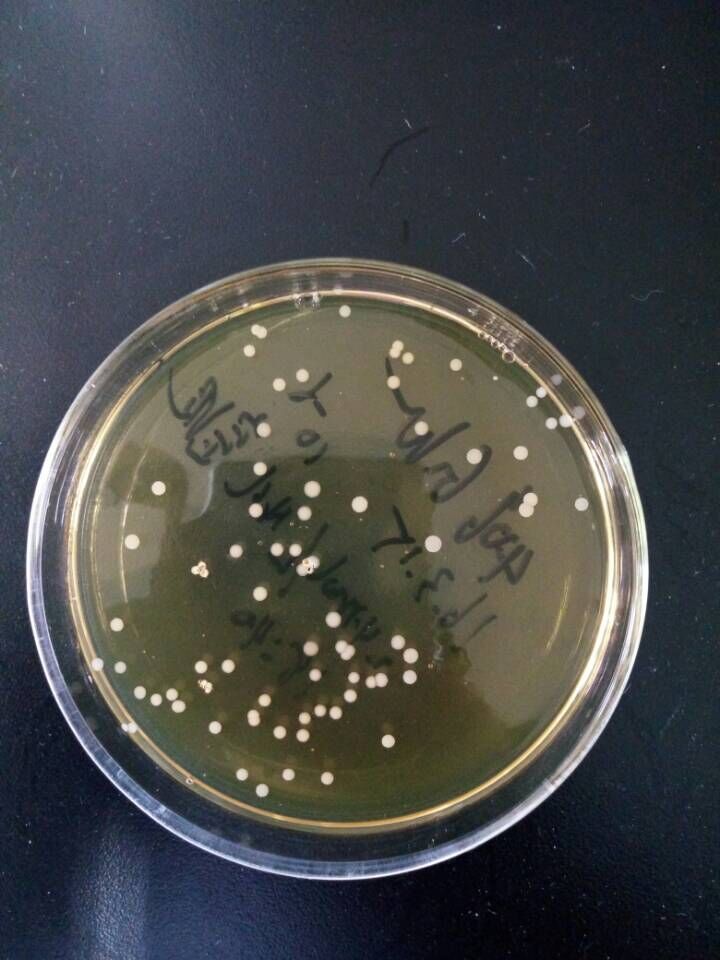

耐高渗酵母菌的筛选以及培养条件的研究毕业论文
2020-05-23 15:57:53
摘 要
以洋河酒厂窖泥为原料,对其进行富级培养,通过不同的盐梯度和糖梯度进行耐高渗酵母菌的筛选。对筛选出的几株菌进行残糖量测定,挑选出发酵性能相对较好的菌株W58,进行菌种鉴定并测定其海藻糖含量以及生长曲线。然后进行单因素试验,研究pH值、温度以及接种量对其生长的影响。根据单因素试验设计L9(33)的正交试验,得出最优的培养条件:温度30℃,pH7.0,接种量为2%。
关键词:耐高渗,酵母菌,筛选,培养条件
Screening of high osmotic pressure tolerance yeast and research of culture conditions
Abstract
Using Yanghe winery cellar mud as the raw material,made the level for its rich culture,and then through the different salt gradient and sugar gradient screened of hypertonic resistance yeast.Determining amount of residual sugar of several strains to pick out the fermentation performance which was relatively good strains---W58.After species identification,determine the trehalose content and the growth curve of W58.And then it was the single factor experiment, testing the effect of the pH, temperature and quantity on their growth.According to single factor experiment,designed L9 (33) orthogonal test,and it was concluded that the optimal culture conditions: temperature 30 ℃, pH7.0, inoculation amount to 2%.
Key words: high permeability resistance, yeast, screening, culture conditions.
目 录
摘 要 I
Abstract II
第一章 引言 1
1.1 窖泥的概述 1
1.2 酵母菌的概述 1
1.3 影响酵母菌生长的因素 2
1.3.1 温度 2
1.3.2 pH值 2
1.3.3 氧气 3
1.3.4 水 3
1.3.5 渗透压 3
1.4 酵母菌的发酵过程 4
1.5 耐高渗酵母菌的耐渗机制 4
1.6 耐高渗酵母菌的研究进展 6
第二章 材料与方法 7
2.1 材料 7
2.1.1 来源 7
2.1.2 培养基 7
2.1.3 仪器设备 8
2.2 实验方法 8
2.2.1 富集 8
2.2.2 初级筛选 9
2.2.3 酵母菌残糖量的测定 9
2.2.4 菌种鉴定 9
2.2.5 酵母菌胞内海藻糖含量的测定 11
2.2.6 生长曲线的测定 11
2.2.7 单因素实验 11
2.2.8 正交试验 12
第三章 结果与讨论 13
3.1 富集的酵母菌菌落观察结果 13
3.2 初筛结果 13
3.2.1 耐盐度筛选 13
3.2.2 耐糖度筛选 14
3.3 酵母菌残糖量的测定 16
3.4 W58的菌落观察和镜检结果 17
3.4.1 W58的菌落 17
3.4.2 W58的镜检结果 18
3.5 26Sr DNA 序列分析 18
3.6 胞内海藻糖含量的测定 20
3.7 耐高渗酵母菌的生长曲线测定结果 21
3.8 温度、pH值和接种量对耐高渗酵母菌生长特性的影响 22
3.8.1 温度对耐高渗酵母菌生长特性的影响 22
3.8.2 pH值对耐高渗酵母菌生长特性的影响 23
3.8.3 接种量耐高渗酵母菌生长的影响 24
3.9 正交试验结果 25
结语 27
参考文献 28
致谢 30
第一章 引言
随着工业化的发展,食品、药品、饮料等产业的生产途径越来越趋向于微生物发酵法。相较于化学合成法,微生物发酵法有着污染低、产率高和可塑造性大等优点[1]。以酒精生产为例,利用化学合成法生产出来的酒精一般混有高级醇类等杂质,因而被称为化工酒精,仅用于化工生产中,而不是酒精饮料或医药用酒精生产[2]。
在微生物发酵法中,菌种乃是微生物发酵法中的核心主体,也是产品的生产机器。因而在微生物发酵法的方法优化研究中,作为生产机器的菌种的筛选以及培养条件是研究的中心环节。本文以酵母菌为研究对象,主要研究筛选其变异的耐高渗菌株,并为了实现现代化的大规模生产,对筛选出的菌株的培养条件进行进一步的研究。
1.1 窖泥的概述
随着酒精生产工业化进程的发展,对酒精生产的方法和条件的研究及优化便从未停止过步伐。从古至今,酒厂生产酒精的方法都是微生物发酵法。微生物发酵法主要是利用酵母菌发酵生产酒精,甚至进一步生产醋酸等,形成一套产业链[3]。
本文实验者从洋河酒厂的窖泥中提取酵母菌,经富集培养后进行耐高渗菌株的筛选和培养条件研究。根据生产的酵母菌生长和发酵所需要的条件,往窖泥中源源不断地加入营养物质,能促进窖泥的新陈代谢。通过培养养分的不断渗入,窖泥中适宜菌种生存、生长、繁殖以及发酵的环境条件得以维持,经过长时间的培养,形成了富含菌种的载体。同时,被源源不断注入不止有提供的养分,还有补充的菌种,因而实现了窖泥的新陈代谢,从而拥有了生产工业化的经济价值[4]。
1.2 酵母菌的概述
“酵母菌”并非是指按照系统分类法命名的某一真菌的学名或名称,它是一类单细胞真菌(子囊菌、担子菌等几科单细胞真菌)的通称,常用于酒精发酵、制作面包等工艺中,但是,有些酵母菌也是致病菌,如白色念珠菌。酵母菌是兼性厌氧真菌,在有无氧气的环境下均能存活,其细胞直径为(2.5-10)×(4.5-21)μm,形状包括球状、椭圆状、卵圆状、柱状以及香肠状等[8]。酵母菌的菌落与细菌相似,一般呈现湿润、透明、容易挑起、质地均匀,并且正面的颜色以及边缘的颜色与中央部位的颜色较为一致。酵母菌的菌落颜色多为乳白色或矿烛色,但也有少数菌落呈现出红色[5]。
酵母菌是人类第一种家养微生物,我们的日常生活都离不开酵母菌,我们利用酵母菌进行酒类生产、面包烘焙、燃料酒精以及甘油的生产,酱油的制作、石油或油品的脱蜡以及饲料添加剂的生产也与酵母菌息息相关。
相关图片展示: